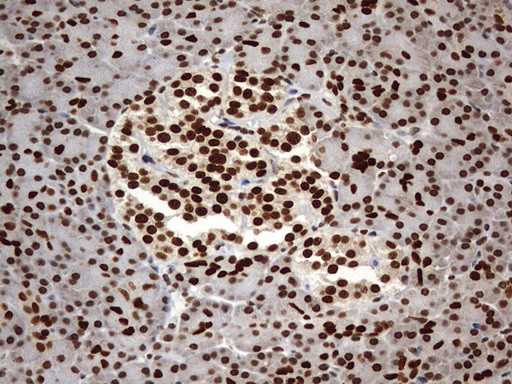
H2AFY2 Antibody in Immunohistochemistry (Paraffin) (IHC (P))

Search
OriGene
H2AFY2 Monoclonal Antibody (OTI1E9), TrueMAB™
{{$productOrderCtrl.translations['antibody.pdp.commerceCard.promotion.promotions']}}
{{$productOrderCtrl.translations['antibody.pdp.commerceCard.promotion.viewpromo']}}
{{$productOrderCtrl.translations['antibody.pdp.commerceCard.promotion.promocode']}}: {{promo.promoCode}} {{promo.promoTitle}} {{promo.promoDescription}}. {{$productOrderCtrl.translations['antibody.pdp.commerceCard.promotion.learnmore']}}
产品信息
TA803388
种属反应
宿主/亚型
分类
类型
克隆号
抗原
偶联物
形式
浓度
纯化类型
保存液
内含物
保存条件
运输条件
靶标信息
Variant histone H2A which replaces conventional H2A in a subset of nucleosomes where it represses transcription. Nucleosomes wrap and compact DNA into chromatin, limiting DNA accessibility to the cellular machineries which require DNA as a template. Histones thereby play a central role in transcription regulation, DNA repair, DNA replication and chromosomal stability. DNA accessibility is regulated via a complex set of post-translational modifications of histones, also called histone code, and nucleosome remodeling. May be involved in stable X chromosome inactivation.
仅用于科研。不用于诊断过程。未经明确授权不得转售。
篇参考文献 (0)
生物信息学
蛋白别名: Core histone macro-H2A.2; core histone macroH2A2.2; H2A histone family, member Y2; Histone macroH2A2; histone mH2A2; mH2A2
基因别名: H2AFY2; MACROH2A2
UniProt ID: (Human) Q9P0M6
Entrez Gene ID: (Human) 55506